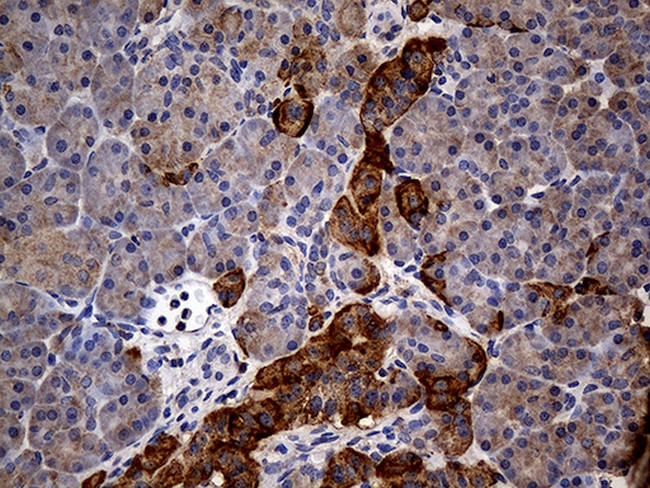
GRB10 Antibody in Immunohistochemistry (Paraffin) (IHC (P))
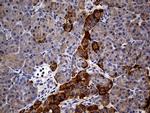
GRB10 Antibody in Immunohistochemistry (Paraffin) (IHC (P))

Search
OriGene
GRB10 Monoclonal Antibody (OTI5A6), TrueMAB™
{{$productOrderCtrl.translations['antibody.pdp.commerceCard.promotion.promotions']}}
{{$productOrderCtrl.translations['antibody.pdp.commerceCard.promotion.viewpromo']}}
{{$productOrderCtrl.translations['antibody.pdp.commerceCard.promotion.promocode']}}: {{promo.promoCode}} {{promo.promoTitle}} {{promo.promoDescription}}. {{$productOrderCtrl.translations['antibody.pdp.commerceCard.promotion.learnmore']}}
产品信息
TA812343
种属反应
宿主/亚型
分类
类型
克隆号
抗原
偶联物
形式
浓度
规格
纯化类型
保存液
内含物
保存条件
运输条件
靶标信息
GRB7, a SH2 domain protein, has a single SH2 domain at its C-terminal, a central region with similarity to Ras GAP, and a proline-rich N terminus. A related SH2 domain-containing protein, GRB10, exhibits a high degree of homology with GRB7. GRB10 undergoes serine but not tyrosine phosphorylation in response to EGF treatment, but appears to bind to the EGF receptor poorly. GRB10 maps to mouse chromosome 11, in close proximity to the EGF receptor. Similarly, GRB7 maps to the same mouse chromosome near the EGF receptor-related protein HER2.
仅用于科研。不用于诊断过程。未经明确授权不得转售。
篇参考文献 (0)
生物信息学
蛋白别名: Grb-IRgamma/hGrb10gamma; GRB10 adapter protein; GRB10 adaptor protein; Growth factor receptor-bound protein 10; Insulin receptor-binding protein Grb-IR; KIAA0207; maternally expressed gene 1; OTTHUMP00000197988; OTTHUMP00000197989; OTTHUMP00000197990; OTTHUMP00000197991; OTTHUMP00000197993; OTTHUMP00000197994; SH2 domain; SH2 domain containing protein; splice variant of Grb10; unnamed protein product
基因别名: Grb-10; GRB-IR; GRB10; GRBIR; IRBP; KIAA0207; MEG1; RSS
UniProt ID: (Human) Q13322
Entrez Gene ID: (Human) 2887